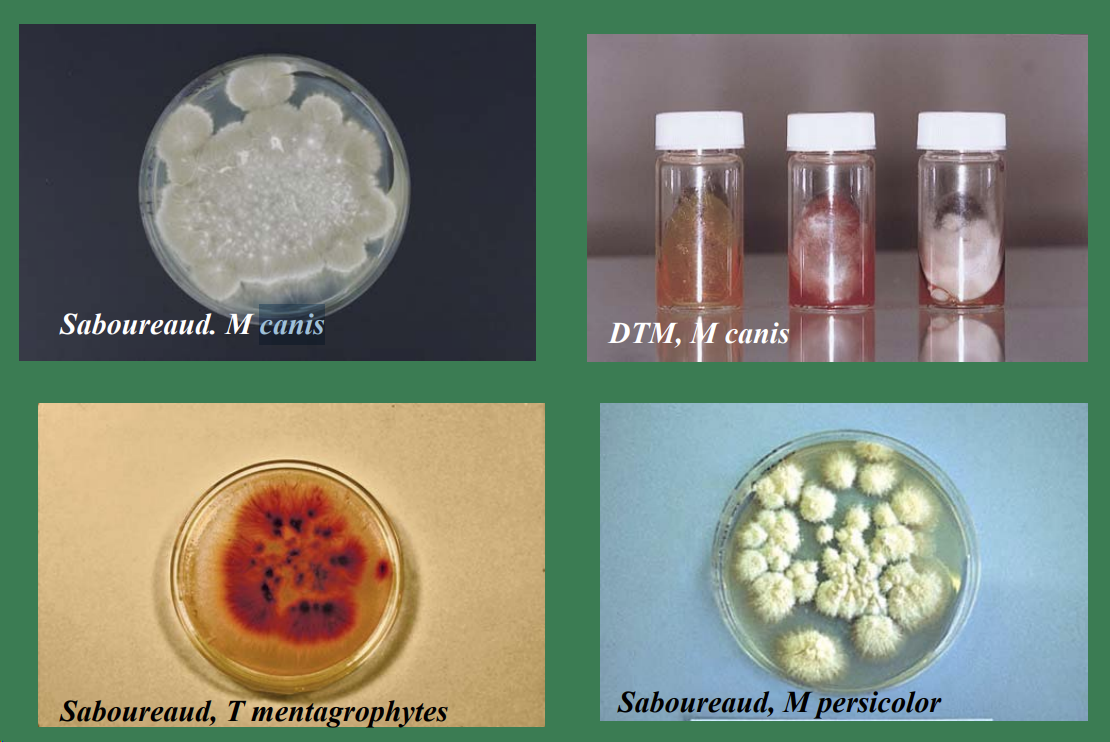

Tema 8 - Pruebas para el diagnóstico en dermatología veterinaria Archivo
Clase del 06/10 M. Teresa Verde Presentación
DERMATOLOGÍA VETERINARIA – PROTOCOLO DIAGNÓSTICO
Pruebas laboratoriales en Dermatología
1. Pruebas básicas laboratoriales
a. Cepillado de pelo y piel
- Procedimiento
- Paciente sobre mesa con papel blanco.
- Uso de peine de púas finas y densas.
- Muestra colocada sobre placa de Petri.
- Observación de la muestra
- Directa con lente de mano (pulgas, piojos).
- Microscopio con muestra en porta + aceite (Cheyletiellas, liendres de piojos).
- Sobre papel absorbente o algodón (sospecha de heces de pulgas).
1.1 - Raspados cutáneos
- Material
- Bisturí, cubre, porta, humectante, microscopio.
- Humectantes: aceite mineral, parafina, KOH 10%.
- Indicación
- Diagnóstico diferencial de ectoparásitos.
- Examen
- Inmediato tras recogida (no envío de muestras).
- Observación: Demodex, Sarcoptes, Cheyletiella.
Observación de la muestra – Demodex
- Raspado de áreas con lesiones recientes.
- Evitar zonas con costras o exudado.
- Realizar varios raspados en distintas zonas.
- Presionar el pliegue para extraer Demodex del folículo.
- Diagnóstico positivo: numerosos adultos y formas inmaduras.
- Falsos negativos en lesiones crónicas → biopsia.
Observación de la muestra – Sarcoptes
- Raspado de bordes de orejas, codos y piel con pápulas/costras.
- Parásito en túneles bajo la epidermis.
- Raspados profundos (mínimo 10).
- Diagnóstico positivo: observación de un individuo o huevo.
- Raspado negativo no excluye diagnóstico.
Observación de la muestra – Cheyletiella
- Parásito grande, superficial (“caspa andante”).
- Raspados superficiales en zonas descamadas.
- Diagnóstico positivo: observación de un adulto o huevo.
1.2 - Impresión con cinta adhesiva transparente
- Material
- Cinta adhesiva transparente, porta, microscopio.
- Indicaciones
- Observación de parásitos superficiales.
- Zonas difíciles de raspar, pequeños mamíferos.
- Observación de Malassezia pachydermatis (si se tiñe).
- Identificación de macro/microconidias de dermatofitos en cultivos.
- Observación de queratinocitos y bacterias.
1.3 - Tricografía (examen microscópico del pelo)
- Procedimiento
- Arrancado de pelos de raíz, colocación en porta con aceite.
- Observaciones
- Huevos de ectoparásitos adheridos (piojos, Cheyletiella).
- Raíz: proporción bulbos anágen/telógen.
- Bulbo anágen: redondeado, liso, brillante.
- Bulbo telógen: afilado, rugoso.
- Puntas: intactas o en brocha (autotraumas).
- Tallo: defectos morfológicos (tricorrexis nodosa), esporas, hifas, huevos.
- Gránulos anómalos de melanina (distrofias de color).
- Manguitos foliculares.
- Ejemplos
- Pelos infestados por M. canis → artrosporas ectotrix alrededor del pelo.
- Pelos infestados por T. mentagrophytes → artrosporas en cadenas.
1.4 - Identificación de dermatofitos
Cultivo micológico
- Recogida de muestra
- Bordes de lesión, pelos, escamas (pinzas, moqueta, cepillo, lámpara Wood).
- En gatos asintomáticos portadores → método del cepillo.
- Medios de cultivo
- Sabouraud, DTM (cicloheximida, gentamicina, clortetraciclina, rojo fenol).
- Metabolitos alcalinos a partir de proteínas del medio.
- Duración: 7 días a 4 semanas.
- Colonias
- Blancas algodonosas o harinosas.
- Observación de macroconidias.
- Ejemplos de cultivo
- M. canis, T. mentagrophytes, M. persicolor.
Lámpara de Wood
- Características
- Alta correlación positiva con M. canis o Microsporum canis (gatos).
- Luz ultravioleta 253 nm.
- Observar paciente en sala oscura durante mínimo 3 minutos
- Positivo: fluorescencia amarillo-verdosa (metabolitos producidos por el hongo)
- Falsos positivos: Pseudomona aerugiosa, Corynebacterium, queratina y algunos jabones
- Falsos negativos: Tratamientos previos con fungicidas tópicos (povidona, captan)

No comments to display
No comments to display